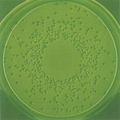
ウイルスや病原菌

医療機関の基礎的なニーズに応える技術
医療の基礎的なニーズに応える有用性の高い製品、服薬コンプライアンス向上を目指した製品、また医療において必要不可欠な感染対策に関わる殺菌消毒薬や関連製品を提供するために、当社では自社内で基礎研究から製剤の開発・改良まで、エビデンスに基づいた柔軟な発想で取り組んでいます。
また、製品容器や周辺機器についても、医薬品の効果や品質の確保のみならず、安全性・使いやすさ・環境に配慮したデザインを追求しています。

医療の基礎的なニーズに応える有用性の高い製品、服薬コンプライアンス向上を目指した製品、また医療において必要不可欠な感染対策に関わる殺菌消毒薬や関連製品を提供するために、当社では自社内で基礎研究から製剤の開発・改良まで、エビデンスに基づいた柔軟な発想で取り組んでいます。
また、製品容器や周辺機器についても、医薬品の効果や品質の確保のみならず、安全性・使いやすさ・環境に配慮したデザインを追求しています。